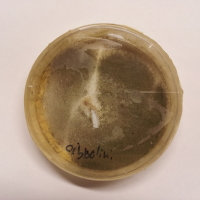
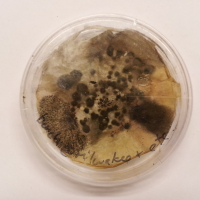
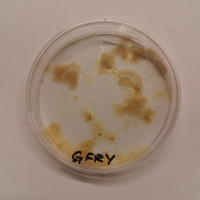
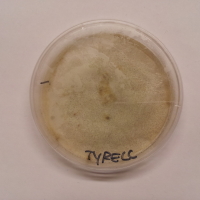

Projects
Baltic Shadows @ MAPP_MTL (2025)
Experimental Video (360 Degrees, click to navigate). An initial experiment/exploration of ancient symbols and nationalism across cultures. Pictured is footage of contemporary Baltic shadows, formed into a Latvian “Zalktis” symbol with laser accents. Sound is Latvian and Quebecois folk songs: epic songs of “Ethnic” whiteness. Screened and documented with thanks to Minute_Mapp_MTL Festival. Thanks to Avalon O’Henley for assistance.
Angles of Consequence (2023-ongoing)
Based on my previous work with reflected sunlight, I am producing a season of site-specific performances with Canadian performers, inviting them to respond to key sites of climate advocacy and destruction. This project is funded by the Social Sciences and Humanities Council of Canada and is supported by the Performing Arts Research Cluster (LePARC) at the Milieux Institute at Concordia University. More information on the project website.
Moisture Recycling (salty queer hydrologies) (2023)

Curated by William Cordova
On Display at Under the Bridge Art Space November 26 2023- January 7th 2024
Artist Meghan Moe Beitiks presents a series of small works reflecting on water as a physically, emotionally and ecologically ubiquitous entity. Water as everything, gathered. Water as absorbing and cleaning. An attempt to pull water as love from the air.
Wetlands is two chairs with basshakers installed under the seats. Visitors encouraged to sit and let the vibrations pass through their bodies.
The speakers rumble with the resonance from 3 microphones which are picking up vibrations from 3 separate boot trays, all of which have a watery soundtrack playing through them. The boot trays have the raised pattern of a text of a recent Florida bill set within them. Included in the soundtrack is the voice of Bebe Deluxe, a Florida-based trans drag performer, who Beitiks asked to respond to the three phrases. Each boot tray has its own soundtrack, set to its own Beats per Minute: 79 for the number of anti-LGBTQ+ and hate crimes in Florida since 2019, 50 for the number of lives lost in the PULSE shooting (49 +1), 60 for the low resting heart rate of the average human.
Each accompanying diagram places the phrases from the Florida laws with other research and statements within hydrologic cycle illustrations from various scientific research papers. Visitors are invited to stand in the boot trays as they read the explanatory diagrams. One diagram, based on hydrology and wetland function, gives a conceptual overview of the entire piece.
Boot trays, while rare in warmer climates, are commonly used in northern areas like Canada to catch the melting snow from boots once they are brought indoors. “Snowbirds” who spend winters in Florida, contributing the economy but not living in the state year-round, may be familiar with them.

From the Baroness (This is Water) is a dehumidifier channeling water into natural sponges. Visitors are encouraged to take a bottle (engraved with an imperfect silhouette of Lake Okeechobee, Hitchiti for “water” + “big”), and squeeze some water into it with the funnels provided. The work rests on a tablecloth with a pattern based on several stages of Lake Okeechobee’s planned watershed restoration: the original watershed flow, and the current flow. A nod to Elsa Baroness von Freytag-Loringhoven, the originator of the readymade, as professed by Duchamp in a letter to his sister (1917, Jean Crotti papers, 1913-1973, Archives of American Art, Smithsonian Institution).
Hydration (self-care). Is a two-part piece. A reflective frame of desalinated seawater, etched with the word “HYDRATE,” paired with a pile of salt packets, in the equivalent weight of the SIG sauer MCX, the weapon used in the PULSE shooting, in a nod to the work of Félix González-Torres. Visitors are welcome to take salt away with them. The desalinated water will evaporate slowly over the course of the show: those who take a bottle From the Baroness may walk away with some of it via the dehumidifier.
Boundaries. Several varieties of the native Floridian Acanthocereus Tetragonus cactus in a tall planter with the word “NO” painted on it. In its smaller varieties, A. Tetragonus is known as the “fairy castle” cactus. It its larger varieties it is known as the “barbed-wire” or “dildo” cactus, most prominent on Florida’s “Dildo Key.” The cacti sit under a solar-powered halo light, and a grow light timed with the local sunrise.
Both Hydrate (self-care) and Boundaries are accompanied by a diagram based on a desalination process.






















All Contested Phrases: An Aria (2022)
University of Florida faculty and community create conceptual aria from censored phrases
UPDATE: As of November 17th, 2022, federal judge has blocked the “Anti-Woke” Bill. Support the ACLU in continued efforts by buying aria merch on bonfire!
In response to efforts to impose censorship by the Provost at the University of Florida, a group of UF Faculty and community members have devised a creative performance using challenged language as the text for a contemporary aria. The aria, based in part on elements of compositions by the twentieth-century Russian composer Dmitri Shostakovich, draws ironic parallels between the state government and authoritarian legacies of censorship. It was performed April 15th, 2022 at Dad’s Bar in Gainesville, Florida, local to the university, as well as streamed online.
In anticipation of political initiatives of the state, the provost of the University of Florida asked university lawyers to review the College of the Arts’ Meta-Strategy. The Meta-Strategy was collaboratively written by college faculty to sharpen the college’s focus, planning, efforts, and funding over the next five years. It included the following phrases:
- unsettle
- deeply inequitable access to power
- systemic change
- correcting exclusionary and repressive systems
- undo systemic oppression and marginalization
- dismantle obstacles to AEI ingrained in our curriculum
- truth, and reconciliation
- negotiations of power and privilege as defined by organizational structures in the College of the Arts
- power analysis
- racial equity spheres to identify and document institutional practices that are barriers to a thriving pluralistic multicultural diversity
- micro-aggression
- Examine and reposition Western, white, male privilege implicit in the foundations of the style, techniques, and methodologies of historical works and traditional performance and practice. Address cultural differences within the disciplines represented in COTA
- eliminating discrimination and other forms of oppression
- AEI criteria at the ULO level
- provocative participation
- power and privilege
- negotiations of power and privilege
- barriers to a thriving pluralistic multicultural diversity
- prepare to or continue to engage race and racism curricularly
College faculty were asked by the provost to “reconsider” these terms. In this context, that consisted of a request to rewrite–academic censorship. In response, the faculty voted to convene a committee to review the document.
As a reaction to this pressure, a partially anonymous group of UF Faculty and community members gathered to turn the phrases “of concern” into their own melodic, conceptual performance, giving these words space to breathe on their own terms.
The music, composed by Florida musician Stephen Germana, combines elements of Shostakovich and Mahler in looping, electronic rhythms. The phrases of concern are sung by Brooklyn-based vocalist Kayleigh Butcher.
The performance includes projections and spoken word by Florida native artist Kenya (Robinson), production, and scholarly context by anonymous community members, and a movement-based response from dancer and UF faculty member Trent Williams.
A live performance of the Aria took place on April 15th at 8pm at Dad’s Bar, a local Gainesville venue supportive of community events: it was also livestreamed on Twitch.tv, Facebook and Instagram.
For inquiries, contact: Meghan Moe Beitiks, mobeitiks (at) gmail.com
RESOURCES
- Watch recordings of the stream on:
- Audio Samples of composition:
- Buy merchandise of the score, benefiting the ACLU:
- Dad’s Bar: https://www.instagram.com/dadsbar/
- About the UF College of the Arts Meta-Strategy:
- Press Kit here.
About the Cast & Crew:
Composer Stephen Germana: https://www.stephengermana.com/aboutnews
Soloist Kayleigh Butcher: http://www.kayleighbutcher.com/
Dancer Trent Williams: https://arts.ufl.edu/directory/profile/39257
Spoken Word and Projection Design by Kenya (Robinson): https://www.privilegeasplastic.com/
Producer Meghan Moe Beitiks: www.meghanmoebeitiks.com
The support team includes several anonymous members of the UF faculty and community, who have chosen not to reveal their names in order to avoid political backlash from within Florida and UF.
More on recent legislation on education in Florida:
Though many of these bills target K-12 schools, university administrators made a concerted effort to impose them on higher education, in part due to fears of backlash from the state. As of November 17th, 2022, a federal judge has blocked the “Anti-Woke” bill from higher education, but much harmful legislation remains in place: buy merch to support the ACLU and its efforts.
- HB 233:
- “Don’t Say Gay” Bill, HB 1557:
- “Anti-Woke” Bill: HB 7:
Shut Up (2022)

Shut Up is a meditation on light and confinement. Drawing upon previous work with reflections, breath, trauma, and self-awareness, I redirect light from the NARS Foundation Project Space window with mirrors and reflective surfaces. Patterns in the space, from mirrored pixels to rotating displays to sequined pillows, are based on pixelations of the surface of the sun. A meditation on time, celestial bodies, isolation and ecologies in the pandemic.
As a closing event for the exhibition, on March 22 at 5pm, I will read an excerpt from her book Performing Resilience for Systemic Pain, recently published with Routledge, in the space as the sun sets, and discuss it friend Stephanie Acosta and visitors.


































































Untitled (Desert Refractions) (2021)

Untitled (Desert Refractions)(2021) is a sculpture, installation and performance created in response to the reflective glass surfaces of many Las Vegas Resorts, the desert environment, the arc of the sun, and the poem Ozymandias. The work explores reflection, opulence, sunlight, legacy, and the impermanence of power. Devised with local performers, the piece included both pre-recorded and live-streamed light as the Las Vegas sun set in real-time.
Sound Structure: Stephen Germana
Sculpture: Meghan Moe Beitiks x Luis Varela-Rico
Rogers Art Loft: Lance Smith, Ryan Reid, Spencer Haley
Cameras: Shahab Zargari, Spencer Haley
Ozymandias
I met a traveller from an antique land,
Who said ‘Two vast and trunkless legs of stone
Stand in the desert. . . . Near them, on the sand,
Half sunk a shattered visage lies, whose frown,
And wrinkled lip, and sneer of cold command,
Tell that its sculptor well those passions read
Which yet survive, stamped on these lifeless things,
The hand that mocked them, and the heart that fed;
And on the pedestal, these words appear:
My name is Ozymandias, King of Kings;
Look on my Works, ye Mighty, and despair!
Nothing beside remains. Round the decay
Of that colossal Wreck, boundless and bare
The lone and level sands stretch far away.’

Untitled (Desert Refractions) sculpture, a collaboration with Luis Varela-Rico, permanently installed at Rogers Studio Gallery. Each of the gold panes of glass points towards a major resort with gold windows. Excerpts from the poem Ozymandias are sandblasted into the glass with industrial garnet and sand from the nearby Red Rock Canyon desert. Detailing with pyrite grit and fake gold spraypaint. The piece changes depending on the angle of the sun. Solar lights illuminate the sculpture at night.
























Untitled (Desert Refractions) long-term installation of gold/silver window film at the Rogers Studio Gallery. The windows of the Studio Gallery take on the reflective quality of opulent local resort windows.







Points of Light (2021)
A livestreamed performance created for pandemic survival with Ray Oppenheimer for Out of Site and the Experimental Sound Studio, re-performed for the Reconnect Festival.
RBG/GDR/RGB (2020)
Recording of livestream performance, originally hosted by Online Performance Art
/Ruth Bader Ginsberg/Great Diurnal Range/Red Green Blue/
December 12th, 2020 was the 20th anniversary of Bush vs. Gore, when the Supreme Court was made to make a definitive decision on the outcome of the 2000 election. December 12th was also when Ruth Bader Ginsberg (RBG) made her famous “dissent”statement, writing from the minority position “I dissent” rather than the traditional “I respectfully dissent,” in protest of the outcome. RGB/GDR/RBG is a durational performance, a brutal engagement with time, and an opportunity to meditate on everything that has changed and been lost in 2020. On December 12th, artists Meghan Moe Beitiks and Ray Oppenheimer sat on opposite coastal states with significant electoral votes: Florida and California. Using the projection design program Isadora, the artists projected an image of Ginsberg’s “Dissent” collar on their own collarbones. The images of the collar changed in color (RGB) based on the date from their collaborator’s tides. In California, Ray’s collar changed according to Florida tides. In Florida, Moe’s collar changed according to California tides. The performance lasted 34 minutes, one minute for every additional electoral vote Biden received over Bush’s 271 electoral votes. The tidal data was drawn from predictions for levels between December 12th, 2020 and January 1st, 2021. The work also included audio and video from cultural ecologies at each site, images of election data and moments, and significant patterns from Ginsberg’s legacy. Beitiks and Oppenheimer enacted meditative spaces and gestures as a reflection on changing tides.
Great Diurnal Range is the difference, in tides, between the height of mean higher higher high water and mean lower low water. RGB is the standard color space for digital screens: Red, Green, Blue. They are also the primary colors of visible light, corresponding to Red, Green and Blue cones in the human eye. Ocean levels are rising. Political changes have profound ecological impacts. A lot has changed in 20 years, but the same fights keep resurfacing. RBG/GDR/RGB seeks to open up a space for reflection on interconnection, change, and political consequences. It seeks to honor the impactful legacy of a significant supreme court justice as a means both of reflecting on the ecological reality of cultural shifts, and meditating on hope for the future.
Ray Oppenheimer is a San Francisco Bay Area based lighting designer, educator, and creator who has been bringing his boundless curiosity, chimerical aesthetic, and sisyphean perseverance to live design and education since 2005. Ray graduated with a Master of Fine Arts in Theatre Arts with an emphasis in lighting design from San Francisco State University in the Fall of 2017. He also is an active company member with Mugwumpin and Shotgun Players.
Sound structure by Stephen Germana, an artist that primarily performs experimental music in an improvisational performance practice that balances between noise, drone, and free jazz. His artistic practice includes algorithmic sound/video, radio transmission, and lens based media. With degrees from School of the Art Institute of Chicago (MFA), University of Miami (MM), and University of Minnesota (BM), he teaches Fine Arts and Art History in South Florida, living in West Palm Beach with his partner Sarah Knudtson and their cats, Roland and Boonmee (Meep).
Performing Public Health (2020)
I am the Lead Facilitator of a project called Performing Pubic Health for the Center for Arts in Medicine, as part of their COVID-19 Arts Response.
From our website:
How do we collectively Perform Public Health? Three overlapping teams of artists, administrators, health officials, academics, researchers and activists offer tools for safe engagement with the arts, chronicle the adaptive powers of artists, and organize resources emerging from artist communities, in an attempt to answer that question.
The Advisory team has created a Performing Public Health Advisory Brief, which offers basic suggestions for safe practices, as well as appendices on infection control recommendations, finding reliable information and links to articles and studies for artists and communities effected by COVID-19.
The efforts include contributions to the COVID-19 Arts Response Repository, helping to chronicle the performance of public health through the arts during the time of the pandemic.
Within these efforts, Remote Cultures emerge in response to the lack of human contact that a pandemic imposes. In this context, Remote Cultures are the artworks, gatherings, adaptations and connections we create when health measures dictate social distance. They are how we maintain closeness, creativity, expression when the space between us is dictated by a virus or a law, or mediated by a screen or mask. Visit this page for a curated focus on the arts adaptive power in the context of a pandemic created by this team.
Within public health measures, the needs of marginalized artists are not always thoroughly considered. They are uniquely precarious, made vulnerable by systemic racism, disability, poverty, compromised immune systems, age, and a number of other factors. Marginalized artists can also possess experiential expertise directly relevant to a pandemic. The Unique Precarities team curates the work of vulnerable artists and communities and places them alongside institutional research, to serve as an interdisciplinary index of creative support. Please visit this page for resources from Uniquely Precarious artists and the systems in which they are entangled.
Performing Public Health considers the specialized concerns of artists and public gatherings at a time when gathering for in-person art experiences is constrained by the possible transmission of an infectious disease like COVID-19. Please visit the resources below for more information.

Graphic Design by Edith Williams.
Performing Public Health
This project was created by the following humans:
- Meghan Moe Beitiks, Artist, University of Florida
- Aaron Colverson, University of Florida
- Chloe Dean, University of Florida
- maxpaº hina minga (charlee huffman), MFA, M.Div. (Kansa/Potawatomi)
- Srinjoyi Lahiri, Young Artivist Alliance
- Keely Mason, University of Florida
- Edith Moore Hubert, Jacksonville University, Linda Berry Stein College of Fine Arts
- Virginia Pesata, University of Florida
- Katrina Pineda, California Representative of the Arts Health Early Career Research Network
- Natalie Rella, University of Florida
- Jill Sonke, University of Florida
- Marina Tsaplina, Transdisciplinary Artist, Health Humanities Scholar, Disability Advocate
- Edith Williams, Graphic Designer
- Kaitlyn Wittig Menguc, Artist & Arts Consultant
We’re also very grateful to our colleagues working in the arts, social work and activism, Arts + Health and Art Place America for their input on the development of this project.
Project Credits and Citations:
- Pesata, V., Moore Hubert, E., Wittig Menguc, K., Beitiks, MM. (2020). Performing Public Health: Advisory. Retrieved from (insert URL).
- Colverson, A., Pineda, K. Lahiri, S. (2020). Performing Public Health: Remote Cultures. Retrieved from (insert URL).
- Tsaplina, M., Beitiks, MM., Huffman, C. (2020). Performing Public Health: Unique Precarities. Retrieved from (insert URL).
Requite (2019)
Created as a workshop performance during Indy Convergence 2019. Romantic comedy audio clips remixed into platonically queer acts of material care between humans and objects of theatricality and light. Full video here.
Tumbleweeds (2014/19)
Misperceptions, cartoonish gestures and desert landscapes. Featuring footage from “Bad Day at Black Rock.” Thanks to Marissa Lee Benedict and Lindsey French.
Untitled (Hinkley) (2014/18)
The re-performance of a single sigh from the 2000 movie “Erin Brockovich,” filmed around the real-life town of Hinkley, California, and infused with imagery and audio from the film. The artist reads text from a 2012 Environmental Impact Report detailing the aftermath from the pollution depicted in the film, and efforts to contain the toxic groundwater plume since the film’s release. With thanks to Marissa Lee Benedict, Lindsey French, Elise Cowin, Christine Shallenberg, and the Center for Land Use Interpretation Desert Research Station. Premieres at CUNTemporary’s Eco Futures Festival as part of DEEP TRASH: Eco Trash on April 19th, 2019.

Flicker Fusion Threshold (2016)
What is the rhythm of seeing breathing?
In order for humans to perceive singular images or bursts of light as continuous, it’s generally thought they should flicker at a rate of 50Hz. Critical flicker fusion rate.[1]
Early films determined that motion appeared continuous at rates of 16 frames per second, to push beyond the distraction of the shutter of a camera. Modern frame rates for digital media are set at 24-60 frames per second. But flicker rates and frame rates are not the same– humans can detect motion at much lower frame rates, and potentially detect flickers and interruptions at rates of 500 Hz.[2]
A lot depends on the intensity of a light or image, and there has been some debate as to exactly how the eye and brain combine moments of stillness into action.
The average resting adult human breathes 12-20 times per minute. Respiratory rate. [3]
In a hospital, nurses may calculate a patient’s breathing rate while measuring their pulse, not alerting the patient to the fact that their breaths are being observed: such awareness could alter the rhythm of their breathing.[4]
The observation of breath is central to many meditation practices. Practitioners of Anapanasanti, a method within Vipassana Meditation, will spend hour-long sessions focused soley on the sensation of their breathing, working to allow other feelings and thoughts to pass. Some studies have suggested that long-term meditation increases the number of gamma neural oscillations in practitioners.[5]
These oscillations are patterns of synchronized communication between neurons in the brain. Gamma waves are detectable in extracellular electric fields between 30-90 Hz. Gamma oscillations are thought to transiently link distributed cell assemblies that are processing related information, a function that is probably important for network processes such as perception, attentional selection and memory. Oscillations.[6]
One study has found that our neural oscillations determine our ability to perceive flashes of light.[7]
What passes in the flicker of a light?
A performance of breath with an EEG headset, and flickering images of animals and Trump supporters breathing. Performed at the Museum of Contemporary Art Chicago as part of MCA Live: aper_ture: admitting the light. Thanks to Ann Meisinger. Photos by Ji Yang. Thanks to Marissa Lee Benedict, Liz Ensz and Lindsey French for an intense few years of personal and artistic growth.
Flicker Fusion Threshold from Meghan Moe Beitiks on Vimeo.
[1] Davis, J. et al, “Humans Perceive flicker artifacts at 500 Hz,†Scientific Reports 5, Article number: 7861 (2015)
[2] Davis, J. et al, “Humans Perceive flicker artifacts at 500 Hz,†Scientific Reports 5, Article number: 7861 (2015)
[3] The Cleveland Clinic, http://my.clevelandclinic.org/health/diagnostics/hic_Vital_Signs, accessed July 31st, 2016
[4] Mooney, Gail P. “Respiratory assessment,†Nursing times, August 13th, 2007, http://www.nursingtimes.net/clinical-archive/respiratory/respiratory-assessment/200191.fullarticle, accessed July 31st, 2016
[5] Lutz, A. et al, “Long-term meditators self-induce high-amplitude
gamma synchrony during mental practice,†PNAS _ November 16, 2004 _ vol. 101 _ no. 46 _ 16373
[6] Colgin, LL. Et al, “Frequency of gamma oscillations routes flow of information in the hippocampus.†2009 Nov 19;462(7271):353-7.
[7] Busch et. Al, “The Phase of Ongoing EEG Oscillations predicts Visual Perception,†The Journal of Neuroscience, June 17, 2009 • 29(24):7869 –7876
Wave Management (2015)
I interviewed Steve Littler, Operations Manager at Biosphere 2, about the function and maintenance of the Ocean Ecosystem’s Wave Machine, and made this video. You can hear the Wave Machine screaming in the background. Thanks to Benedict and French.
Subatomic Systems of Self (2015)

I created a series of images for the PITTsburgh Particle physics Astrophysics and Cosmology Center (PITT PACC) at the University of Pittsburgh. The images pulled stills from the video MicroBooNE system and arranged them on a grid, as in a Neutrino Detector hitmap, accompanied by quotes from philosopher David Galin. The panels measure 2.5′ x 3.5′ x 1/8″ thick.
Observations on Final States in Interactions (2015)
I interviewed four experimental physicists from Fermi National Accelerator Laboratory about their daily interactions with neutrinos, their own experiences of role and identity, and their perceptions of me as a person. The result is four different video installation “systems,†based on those interviews, the detectors, and the four possible identities of neutrinos. Grounding the work is a conversation with David Galin, an author and researcher of the concept of ‘self.’ Within “Observations of Final States in Interactions,†I explore parallels between neutrinos and human concepts of self, the performance of science and scientific research, and what it means for us all to be mutually entangled.
Neutrinos are one of most ubiquitous subatomic particles. Beaming through the empty space in atoms, they are very difficult to detect, defined primarily by the particle they happen to bump into. There are three, possible four, types of neutrinos: Muon, Electron, Tau, and the elusive Sterile, or non-interacting, neutrino.
At Fermilab in Batavia, Illinois, there are four large detectors built to examine neutrino oscillations and interactions: MINOS, MINERvA, NOvA, and MicroBooNE. Each detector looks at different aspects of neutrino interactions and identities: at the heart of the research lie some of the bigger questions for the universe. Why it is made up of matter, for instance. “Observations of Final States in Interactions†is exactly what its title suggests: a series of observations, a drawing of parallels between methods of inquiry, a look at systems of knowing and understanding. It seeks not to answer the profoundly large questions, but only to point out commonalities. Big thanks to Ross Stanton Jordan for curation, as well as Kate Zeller and Georgia Schwender for facilitation.
Observations on Final States in Interactions (Exhibition Photos) from Meghan Moe Beitiks on Vimeo.
Detector Systems (MINOS: Muon, MINERvA: (Tau), NOvA: Electron ) (2015) Video (8:30 mins), projectors, computer speakers, lamps, painted desks, chalk. Featuring interviews with Fermilab Physicists Bill Lee, Mateus Carneiro da silva, Sam Zeller, and Zarko Pavlovic.
MicroBooNE: (Sterile) System (2015): (Video 3:11 mins). Featuring footage of Fermilab Physicist Sam Zeller, and an interview with David Galin, author of “Self, Person and I†in Buddhism and Science: Breaking New Ground.
Dry Erase System (2015): adjacent to MicroBooNE, re-imaginings of Sam-Zellers drawings, infusing descriptions of neutrino research with concepts of “self,†quotes from Galin, Fermi Physicist Bill Lee, Karen Barad.
Chalkboard System (2015): Chalkboard drawings and calculations used in neutrino research. Materials: paint, chalk.
Intra-active Hitmap (2014): Paper, 37†tall, 13.3’ long. Large-scale reimagining of an actual neutrino interaction hitmap from Fermilab. A reflection on the work of the artist and the physicists and the resulting “tracks†of that work.
PRESS:
“It doesn’t take long for visitors to also feel like they are part of the exhibit: neutrinos constantly oscillating and changing.”– Downtown Auroran
“It is easy to become overwhelmed by the layers of Beitiks’ work. However, if approached with the understanding of one or two clear elements, the depth of the exhibit surfaces. Each aspect feeds into the next and the details become clear in how they interact with one another. A significant aspect in this exhibit is the way in which interaction unfolds. It reflects both her process of exploring neutrinos, the physicists who interact with them, and Beitiks’ own interactions with the physicists in their work environment. Through the audio clips and the multiple ways in which the clips stem into other ideas (that then interact with each other) she is exploring the process of how art and science can work together and separately.” — Jorie Senese, Water Street Studios Blog
UPDATE:
The Intra-Active Hitmap (2014) was displayed at Fermi National Accelerator Laboratory for several months following this exhibition (2015/2016).
MicroBooNE System from Meghan Moe Beitiks on Vimeo.
Detector Systems from Meghan Moe Beitiks on Vimeo.
GM Canola Trial Run (2014)
While I was in Western Australia in the summer (winter) of 2014, the verdict for a prominent case was announced. An organic farmer’s canola crop had been contaminated by his neighbor’s genetically modified canola. He sued this neighbor, and the court came down against him. I interviewed a canola farmer who was growing conventional and genetically modified canola side by side, and a farmer who is decidedly against genetic modification. An exploration of communication and relationships in the context of environmental management. No GM canola pollen or seed was intentionally spread in the making of this film: I run through non-GM fields. Thanks to Perdita Phillips.
Embracing the Void (2014)
I hug the void within Double Negative (Michael Heizer 1969-70). Photo by Lindsey French.
Trailer: (2013)
I asked staff and fellows at Ox-Bow during the summer of 2013 to describe to me their favorite scenes in movies. Then I used those descriptions to prompt performances with the landscape, and spliced those moments into their own trailer. The expanded short film has been in exhibition at Womanmade Gallery in Chicago.
Trailer: in process from Meghan Moe Beitiks on Vimeo.
Trans-Plantable Living Room (2013)
In September 2013 I was in the UK working on The Trans-Plantable Living Room with Tanja Beer, Rosie Leach, Lisa Woynarski and Bronwyn Preece.
Rosie interviewed gardeners in Cardiff, Tanja designed a grown living space, and Lisa, Bronwyn and I developed a performance in response to both. It premiered in Cardiff at the World Stage Design Conference followed by an adaptation at the Central School for Speech and Drama’s Collisions Conference. We explored what it means to garden in a global and local sense.
The project evolved over a series of months, with Bronwyn, Lisa and I first creating a video in response to Rosie’s interviews. The gardeners interviewed were deeply involved in the build and implementation of the piece in Cardiff.
UPDATE: This work was featured in an exhibition on UK Design for Performance at the Victoria and Albert Museum, with a lens on the work of Tanja Beer. Lisa Woynarski and Bronwyn Preece have also written about the work for Contemporary Theatre Review.
trans-planted tea sets from Meghan Moe Beitiks on Vimeo.
image credits: Gisela Beer, Nigel Pugh
Needle (2013)
I was lucky enough to have been approached by Anahita Ghazvinizadeh to act in her short film Needle. The film maps a moment in time with a girl whose family is going through a divorce. The simple act of piercing her ears takes on greater meaning. I play the mother. The film recently won the Cannes Film Festival Cinefoundation Prize, the highest award for a student filmmaker, and has screened in many other film festivals.
“Moe Beitiks makes the mother quite human even if she is all germophobia and egotism”– Jay’s Movie Blog
Microboundaries (2013)
Microboundaries is a game designed to help you experience two things: the needs of beneficial bacteria, and new places and perspectives in your urban environment.
There are 5 bacteria to choose from. Each of them provides a unique and beneficial service to us and our world. Some of them live in the earth’s crust, others in deep water or amongst the roots of plants. Their work is ever-present and invisible. Each of them has an icon designed by my collaborator Brooke Collins.
Micro-Boundaries asks: where would this bacteria live in your city? What kind of places can you imagine that it might like? How does it become present in your world?
Take a photo of a place that fits the criteria for that bacteria with Instagram. Upload with your photo map on and hashtag the bacteria type. Colonize your city with microbes. Discover new places in your city, gain new perspective, help spread the word about the good work of these ‘bugs’.
Car-E-Oke (2012)
In “Car-E-Oke,” you can choose the make and model of a car and sing along to its exhaust sounds. Regular engine noises have fun karaoke subtitles. But there’s a catch: the sound system is bike-powered. Visitors are encouraged to hop on the bike and “pedal-power” the PA. In addition, I bike every other day of the exhibition, wearing bike shorts, a sequined top, shiny sunglasses, and a fanny pack that emitted sound tracks from classic car chase movies. The sound of the car engine is acknowledged as a kind of soundtrack to our lives.
Microbial Portraits (2012)
I am taking cultures from people and places and taking photos of them with a digital microscope. Portraits on a microscopic level. This is for the School of the Art Institute of Chicago GFRY Studio.